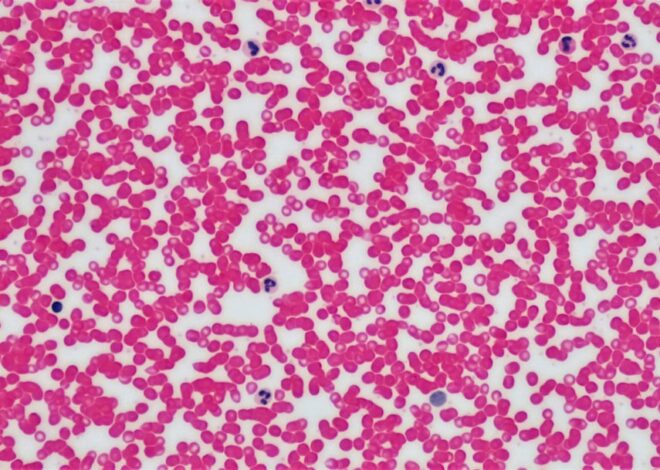
ce este lupusul eritematos sistemic

Cookie & data protection
Acest website foloseşte cookie-uri (atât proprii cât şi de la terţi) pentru a furniza utilizatorilor o experienţă mult mai bună de navigare şi servicii adaptate nevoilor şi interesului fiecăruia.
În ceea ce numim “web 2.0”, “cookie”-urile joacă un rol important în facilitarea accesului şi livrării multiplelor servicii de care utilizatorul se bucură pe internet, cum ar fi:
- Personalizarea anumitor setări precum: limba în care este vizualizat un site, moneda în care se exprimă anumite preţuri sau tarife, păstrarea opţiunilor pentru diverse produse (măsuri, alte detalii etc) în coşul de cumpărături (şi memorarea acestor opţiuni) – generându-se astfel flexibilitatea “coşului de cumpărături” (accesarea preferinţelor vechi prin accesarea butonului “inainte” şi “înapoi”)
- Cookie-urile oferă deţinătorilor de site-uri un feedback valoros asupra modului cum sunt utilizate site-urile lor de către utilizatori, astfel încât să le poată face şi mai eficiente şi mai accesibile pentru utilizatori.
- Permit aplicaţiilor multimedia sau de alt tip de pe alte site-uri să fie incluse într-un anumit site pentru a crea o experienţă de navigare mai valoroasă, mai utilă şi mai plăcută. Îmbunătăţesc, de asemenea, eficienţa publicitaţii online.
Ce este un “cookie”?
Un “Internet Cookie” (termen cunoscut şi ca “browser cookie” sau “HTTP cookie” sau pur şi simplu “cookie” ) este un fişier de mici dimensiuni, format din litere şi numere, care va fi stocat pe computerul, terminalul mobil sau alte echipamente ale unui utilizator de pe care se accesează Internetul.
Cookie-ul este instalat prin solicitarea emisă de către un web-server unui browser (ex: Internet Explorer, Firefox, Chrome) şi este complet “pasiv” (nu conţine programe software, viruşi sau spyware şi nu poate accesa informaţiile de pe hard-drive-ul utilizatorului).
Un cookie este format din 2 părţi: numele şi conţinutul sau valoarea cookie-ului. Mai mult, durata de existenţă a unui cookie este determinată; tehnic, doar web-serverul care a trimis cookie-ul îl poate accesa din nou în momentul în care un utilizator se întoarce pe website-ul asociat webserverului respectiv.
Cookie-urile în sine nu solicită informaţii cu caracter personal pentru a putea fi utilizate şi, în cele mai multe cazuri, nu identifică personal utilizatorii de internet.
- Există 2 categorii mari de cookie-uri:
– Cookieuri de sesiune – acestea sunt stocate temporar în dosarul de cookie-uri al browserului web pentru ca acesta să le memoreze până când utilizatorul iese de pe website-ul respectiv sau închide fereastra browserului (ex: în momentul logării/delogării pe un cont de web-mail sau pe reţele de socializare).
– Cookieuri Persistente – acestea sunt stocate pe hard-drive-ul unui computer sau echipament (şi în general depinde de durata de viaţă prestabilită pentru cookie). Cookie-urile persistente le includ şi pe cele plasate de un alt website decât cel pe care îl vizitează utilizatorul la momentul respectiv – cunoscute sub numele de “third party cookies” (cookieuri plasate de terţi) – care pot fi folosite în mod anonim pentru a memora interesele unui utilizator, astfel încât să fie livrată publicitate cât mai relevantă pentru utilizatori.
Care sunt avantajele cookie-urilor?
Un cookie conţine informaţii care fac legătura între un web-browser (utilizatorul) şi un web-server anume (website-ul). Dacă un browser acceseaza acel web-server din nou, acesta poate citi informaţia deja stocată şi reacţiona în consecinţă.
Cookie-urile asigură userilor o experienţă plăcută de navigare şi susţin eforturile multor website-uri pentru a oferi servicii confortabile utilizatorillor: ex – preferinţele în materie de confidenţialitate online, opţiunile privind limba site-ului, coşuri de cumpărături sau publicitate relevantă.
Care este durata de viaţă a unui cookie?
Cookie-urile sunt administrate de web-servere. Durata de viaţă a unui cookie poate varia semnificativ, depinzând de scopul pentru care este plasat. Unele cookie-uri sunt folosite exclusive pentru o singură sesiune (session cookies) şi nu mai sunt reţinute odată ce utilizatorul a părăsit website-ul si unele cookie-uri sunt reţinute şi refolosite de fiecare dată când utilizatorul revine pe acel website (“cookie-uri permanente”). Cu toate acestea, cookie-urile pot fi şterse de un utilizator în orice moment prin intermediul setărilor browser-ului.
Ce sunt cookie-urile plasate de terţi?
Anumite secţiuni de conţinut de pe unele site-uri pot fi furnizate prin intermediul unor terţe părţi/furnizori (ex: news-box, un video sau o reclamă). Aceste terţe părţi pot plasa de asemenea cookie-uri prin intermediul site-ului şi ele se numesc “third party cookies”, pentru că nu sunt plasate de proprietarul website-ului respectiv. Furnizorii terţi trebuie să respecte de asemenea legea în vigoare şi politicile de confidenţialitate ale deţinătorului site-ului.
Cum sunt folosite cookie-urile de către acest site
O vizită pe acest site poate plasa cookie-uri în scopuri de:
- Cookie-uri de performanţă a site-ului
- Cookie-uri de analiză a vizitatorilor
- Cookie-uri pentru geotargetting
- Cookie-uri de înregistrare
- Cookie-uri pentru publicitate
- Cookie-uri ale furnizorilor de publicitate
- Aceste cookie-uri pot proveni de la următorii terti: Google Analytics, Facebook, Youtube etc
Cookie-uri de performanţă:
Acest tip de cookie reţine preferinţele utilizatorului pe acest site, aşa încât nu mai este nevoie de setarea lor la fiecare vizitare a site-ului. Exemple:
- setările volumului pentru video player
- viteza de video streaming cu care este compatibil browser-ul
Cookie-uri pentru analiza vizitatorilor
De fiecare dată când un utilizator vizitează acest site soft-ul de google analytics furnizat de o terţă parte generează un cookie de analiză a utilizatorului. Acest cookie ne spune dacă aţi mai vizitat acest site până acum. Browser-ul ne va spune dacă aveţi acest cookie, iar dacă nu, vom genera unul. Acesta permite monitorizarea utilizatorilor unici care ne vizitează şi cât de des o fac.
Atâta timp cât nu sunteţi înregistrat pe acest site, acest cookie nu poate fi folosit pentru a identifica persoanele fizice, ele sunt folosite doar în scop statistic. Daca sunteţi înregistrat putem şti, de asemenea, detaliile pe care ni le-aţi furnizat, cum ar fi adresa de e-mail şi user-name-ul – acestea fiind supuse confidentialităţii şi prevederilor din Termeni şi Conditii, Politică de confidenţialitate precum şi prevederilor legislaţiei in vigoare cu privire la protejarea datelor cu caracter personal.
Cookie-uri pentru geotargetting
Aceste cookie-uri sunt utilizate de către un soft care stabileşte din ce ţara proveniţi. Este complet anonim şi este folosit doar pentru a targeta conţinutul – chiar şi atunci când sunteţi pe pagina noastră în limba română sau în altă limbă primiţi aceeaşi reclamă.
Cookie-uri pentru înregistrare
Atunci când vă înregistraţi pe acest site, generăm un cookie care ne anunţă dacă sunteţi înregistrat sau nu. Serverele noastre folosesc aceste cookie-uri pentru a ne arăta contul cu care sunteţi înregistrat şi dacă aveţi permisiunea pentru un serviciu anume. De asemenea, ne permite să asociem orice comentariu pe care îl postaţi pe site-ul nostru cu user-name-ul dvs. Dacă nu aţi selectat “păstreaza-mă înregistrat”, acest cookie se va şterge automat când veţi închide browser-ul sau calculatorul.
Cookie-uri pentru publicitate
Aceste cookie-uri ne permit să aflăm dacă aţi vizualizat sau nu o reclamă online, care este tipul acesteia şi cât timp a trecut de când aţi văzut mesajul publicitar.
Aceste cookie-uri le folosim şi pentru a targeta publicitatea online. Putem folosi, de asemenea, cookie-uri aparţinând unei terţe părţi, pentru o mai bună targetare a publicităţii, pentru a arăta de exemplu reclame despre vacanţe, dacă utilizatorul a vizitat recent un articol pe site despre vacanţe. Aceste cookie-uri sunt anonime, ele stochează informaţii despre contentul vizualizat, nu despre utilizatori.
De asemenea, setăm cookie-uri anonime şi prin alte site-uri pe care avem publicitate. Primindu-le, astfel, noi le putem folosi pentru a vă recunoaşte ca vizitator al acelui site dacă ulterior veţi vizita site-ul nostru, vă vom putea livra publicitatea bazată pe această informaţie.
Alte cookie-uri ale terţelor părţi
Pe unele pagini, terţii pot seta propriile cookie-uri anonime, în scopul de a urmări succesul unei aplicaţii, sau pentru a customiza o aplicaţie. Datorită modului de utilizare, acest site nu poate accesa aceste cookie-uri, la fel cum terţele părţi nu pot accesa cookie-urile deţinute de acest site.
De exemplu, când distribuţi un articol folosind butonul pentru reţelele sociale aflat pe acest site, acea reţea socială va înregistra activitatea dvs.
Ce tip de informaţii sunt stocate şi accesate prin intermediul cookie-urilor?
Cookie-urile păstrează informaţii într-un fişier text de mici dimensiuni care permit unui website să recunoască un browser. Web-serverul va recunoaşte browser-ul până când cookie-ul expiră sau este şters.
Cookie-ul stochează informaţii importante care îmbunătăţesc experienţa de navigare pe Internet (ex: setările limbii în care se doreşte accesarea unui site; păstrarea unui user logat în contul de web-mail; securitatea online banking; păstrarea produselor în coşul de cumpărături).
De ce sunt cookie-urile importante pentru Internet?
Cookie-urile reprezintă punctul central al funcţionării eficiente a Internetului, ajutând la generarea unei experienţe de navigare prietenoase şi adaptata preferinţelor şi intereselor fiecărui utilizator. Refuzarea sau dezactivarea cookie-urilor poate face unele site-uri imposibil de folosit.
Refuzarea sau dezactivarea cookie-urilor nu înseamnă că nu veţi mai primi publicitate online, ci doar că aceasta nu va mai putea ţine cont de preferinţele şi interesele dvs., evidenţiate prin comportamentul de navigare.
- Exemple de întrebuinţări importante ale cookie-urilor (care nu necesită autentificarea unui utilizator prin intermediul unui cont):
– Conţinut şi servicii adaptate preferinţelor utilizatorului – categorii de ştiri, vreme, sport, hărţi, servicii publice şi guvernamentale, site-uri de entertainment şi servicii de travel.
– Oferte adaptate pe interesele utilizatorilor – reţinerea parolelor, preferinţele de limbă (ex: afişarea rezultatelor cautărilor în limba română).
– Reţinerea filtrelor de protecţie a copiilor privind conţinutul pe Internet (opţiuni family mode, funcţii de safe search).
– Limitarea frecvenţei de difuzare a reclamelor – limitarea numărului de afişări a unei reclame pentru un anumit utilizator pe un site.
– Furnizarea de publicitate mai relevantă pentru utilizator.
– Măsurarea, optimizare şi caracteristicile de analytics – cum ar fi confirmarea unui anumit nivel de trafic pe un website, ce tip de conţinut este vizualizat şi modul cum un utilizator ajunge pe un website (ex. prin motoare de căutare, direct, din alte website-uri etc). Website-urile derulează aceste analize a utilizării lor pentru a îmbunătăţi site-urile în beneficiul userilor.
– Securitate şi probleme legate de confidenţialitate
Cookieurile NU sunt viruşi ! Ele folosesc formate tip plain text. Nu sunt alcătuite din bucăţi de cod aşa că nu pot fi executate nici nu pot auto-rula. În consecinţă, nu se pot duplica sau replica pe alte reţele pentru a se rula sau replica din nou. Deoarece nu pot îndeplini aceste funcţii, nu pot fi considerate viruşi.
Cookie-urile pot fi totuşi folosite pentru scopuri negative. Deoarece stochează informaţii despre preferinţele şi istoricul de navigare al utilizatorilor, atât pe un anume site cât şi pe mai multe alte site-uri, cookie-urile pot fi folosite ca o formă de Spyware. Multe produse anti-spyware sunt conştiente de acest fapt şi în mod constant marchează cookie-urile pentru a fi şterse în cadrul procedurilor de ştergere/scanare anti-virus/anti-spyware.
În general browser-ele au integrate setări de confidenţialitate care furnizează diferite nivele de acceptare a cookie-urilor, perioadă de valabilitate şi ştergere automată după ce utilizatorul a vizitat un anumit site.
Alte aspecte de securitate legate de cookie-uri
Deoarece protecţia identităţii este foarte valoroasă şi reprezintă dreptul fiecărui utilizator de internet, este indicat să se ştie ce eventuale probleme pot crea cookie-urile. Pentru că prin intermediul lor se transmit în mod constant în ambele sensuri informaţii între browser şi website, dacă un atacator sau persoană neautorizată intervine în parcursul de transmitere a datelor, informaţiile conţinute de cookie pot fi interceptate. Deşi foarte rar, acest lucru se poate întâmpla daca browser-ul se conectează la server folosind o reţea necriptată (ex: o reţea WiFi nesecurizată).
Alte atacuri bazate pe cookie implică setări greşite ale cookie-urilor pe servere. Dacă un website nu solicită browser-ului să folosească doar canale criptate, atacatorii pot folosi această vulnerabilitate pentru a păcăli browser-ele în a trimite informaţii prin intermediul canalelor nesecurizate. Atacatorii utilizează apoi informaţiile în scopuri de a accesa neautorizat anumite site-uri. Este foarte important să fiţi atenţi în alegerea metodei celei mai potrivite de protecţie a informaţiilor personale.
Sfaturi pentru o navigare sigură şi responsabilă, bazată pe cookies.
Datorită flexibilităţii lor şi a faptului că majoritatea dintre cele mai vizitate site-uri şi cele mai mari folosesc cookie-uri, acestea sunt aproape inevitabile. Dezactivarea cookie-urilor nu va permite accesul utilizatorului pe site-urile cele mai răspândite şi utilizate printre care Youtube, Gmail, Yahoo si altele.
- Iată câteva sfaturi care vă pot asigura ca navigaţi fără griji însă cu ajutorul cookie-urilor:
– Particularizaţi-vă setările browser-ului în ceea ce priveşte cookie-urile pentru a reflecta un nivel confortabil pentru voi al securităţii utilizării cookie-urilor.
– Dacă nu vă deranjează cookie-urile şi sunteţi singura persoană care utilizaează computerul, puteţi seta termene lunigi de expirare pentru stocarea istoricului de navigare şi al datelor personale de acces.
– Dacă împărţiti accesul la calculator, puteţi lua în considerare setarea browser-ului pentru a şterge datele individuale de navigare de fiecare dată când închideţi browser-ul. Aceasta este o variantă de a accesa site-urile care plasează cookie-uri şi de a şterge orice informaţie de vizitare la închiderea sesiunii navigare.
– Instalaţi-vă si updataţi-vă constant aplicaţii antispyware.
Multe dintre aplicaţiile de detectare şi prevenire a spyware-ului includ detectarea atacurilor pe site-uri.
Astfel, impiedică browser-ul de la a accesa website-uri care ar putea să exploateze vulnerabilitatile browser-ului sau să descarce software periculos. Asiguraţi-vă că aveţi browserul mereu updatat. Multe dintre atacurile bazate pe cookies se realizează exploatând punctele slabe ale versiunilor vechi ale browser-elor.
Cookie-urile sunt pretutindeni şi nu pot fi evitate dacă doriţi să vă bucuraţi de acces pe cele mai bune şi cele mai mari site-uri de pe Internet – locale sau internaţionale. Cu o inţelegere clară a modului lor de operare şi a beneficiilor pe care le aduc, puteţi lua măsurile necesare de securitate astel încât să puteţi naviga cu încredere pe internet.
Cum pot opri cookie-urile?
Dezactivarea şi refuzul de a primi cookie-uri pot face anumite site-uri impracticabile sau dificil de vizitat şi folosit. De asemenea, refuzul de a accepta cookie-uri nu înseamnă că nu veţi mai primi/vedea publicitate online.
Este posibilă setarea din browser pentru ca aceste cookie-uri să nu mai fie acceptate sau poţi seta browser-ul să accepte cookie-uri de la un site anume. Dar, de exemplu, dacă nu eşti înregistat folosind cookie-urile, nu vei putea lăsa comentarii.
Toate browser-ele moderne oferă posibilitatea de a schimba setările cookie-urilor. Aceste setări se găsesc de regulă în “opţiuni” sau în meniul de “preferinţe” al browser-ului folosit.
- Pentru a înţelege aceste setări, următoarele link-uri pot fi folositoare, altfel puteţi folosi opţiunea “ajutor” a browser-ului pentru mai multe detalii.
Cookie settings în Internet Explorer http://windows.microsoft.com/en-us/internet-explorer/delete-manage-cookies#ie=ie-11
Cookie settings în Mozilla https://support.mozilla.org/en-US/kb/enable-and-disable-cookies-website-preferences
Cookie settings în Chrome https://support.google.com/chrome/answer/95647?hl=en
Cookie settings în Safari https://support.apple.com/kb/ph17191?locale=en_US
Cookie settings în Opera http://www.opera.com/help/tutorials/
Pentru setările cookie-urilor generate de terţi, puteţi consulta şi site-ul www.youronlinechoices.com/ro/ unde găsiţi mai multe informaţii privind confidenţialitatea legată de publicitatea online.
Date cu caracter personal
Succes Servicii Integrate SRL este deosebit de interesata de respectarea vietii private a vizitatorilor si utilizatorilor paginilor sale de internet.
Acest document descrie practicile adoptate de Succes Servicii Integrate SRL cu privire la datele cu caracter personal pe care compania le poate colecta, utilizarea acestora si persoanele pentru care sunt colectate.
Cu toate acestea, fiecare pagina de internet Succes Servicii Integrate SRL are un obiectiv diferit si caracteristici proprii. Daca un anumit site internet Succes Servicii Integrate SRL solicita date personale suplimentare, veti fi informat in legatura cu acest lucru pe site-ul respectiv.
Date cu caracter personal
In general, puteti accesa paginile internet ale Succes Servicii Integrate SRL fara a fi nevoie sa furnizati informatii cu caracter personal.
Pentru a va satisface nevoile, Succes Servicii Integrate SRL va poate solicita sa furnizati date cu caracter personal, de exemplu, pentru a stabili o corespondenta sau pentru a procesa o comanda.
In special, este vorba de coordonatele dumneavoastra (nume, adresa, numar de telefon, adresa electronica, etc.)
Colectarea datelor cu caracter personal
Succes Servicii Integrate SRL nu colecteaza date cu caracter personal decat in scopuri precise, explicite si legitime si nu prelucreaza apoi aceste date intr-un mod incompatibil cu aceste scopuri.
Atunci cand colecteaza date cu caracter personal, Succes Servicii Integrate SRL informeaza persoana in cauza in momentul sau inainte de colectare si inainte de a le utiliza in scopurile definite.
Succes Servicii Integrate SRL se angajeaza sa nu prelucreze decat date cu caracter personal adecvate, pertinente si neexcesive in raport cu scopurile pentru care sunt colectate. Succes Servicii Integrate SRL va adopta toate dispozitiile necesare pentru ca datele cu caracter personal prelucrate sa fie exacte si actualizate, daca este cazul.
Utilizarea datelor colectate pe site-urile Succes Servicii Integrate SRL.
Succes Servicii Integrate SRL utilizeaza datele cu caracter personal in limita stricta a scopurilor in care au fost colectate.
Drept exemplu, Succes Servicii Integrate SRL va poate solicita date cu caracter personal pentru a:
- Va furniza informatii privind produsele si serviciile
- Executa si urmari tranzactiile dumneavoastra
- Participa la aspectele interactive ale site-urilor
- Comunica si dezvolta relatii comerciale cu dumneavoastra
Succes Servicii Integrate SRL se angajeaza sa nu utilizeze datele cu caracter personal in scopuri de prospectare comerciala fara a obtine in prealabil consimtamantul dumneavoastra.
Destinatarii datelor cu caracter personal
Destinatarii datelor dumneavoastra personale se limiteaza exclusiv la persoanele abilitate sa cunoasca aceste date datorita functiilor pe care le ocupa.
Succes Servicii Integrate SRL va poate cere date cu caracter personal impreuna cu furnizorii sau prestatarii de servicii la care apeleaza Succes Servicii Integrate SRL pentru a va procesa comanda. Acestia din urma sunt obligati contractual sa respecte confidentialitatea si siguranta datelor pe care le pot primi si sa nu le utilizeze decat in scopurile misiunii care le-a fost incredintata.
Succes Servicii Integrate SRL se angajeaza de asemenea sa nu vanda, inchirieze sau cedeze unor terti datele cu caracter personal fara aprobarea dumneavoastra, cu exceptia, in special, a urmatoarelor cazuri: in aplicarea unei decizii judiciare sau administrative, pentru a se conforma legislatiei aplicabile, pentru a proteja drepturile si bunurile Succes Servicii Integrate SRL.
Durata de pastrare
Succes Servicii Integrate SRL pastreaza datele cu caracter personal doar atat timp cat este necesar pentru indeplinirea scopurilor in care au fost colectate sau atat timp cat prevede legea in vigoare.
Dreptul de acces, modificare, stergere si opozitie
Puteti solicita in orice moment ca Succes Servicii Integrate SRL sa va acorde dreptul de acces la datele cu caracter personal care va privesc.
Beneficiati de asemenea de dreptul de modificare sau stergere a acestor date si de dreptul de a va opune, din motive intemeiate, la prelucrarea datelor susmentionate.
In ceea ce priveste prospectarea comerciala, puteti utiliza dreptul de opozitie fara nicio justificare.
Pentru a beneficia de aceste drepturi, adresati-va administratorului site-ului internet in cauza si/sau responsabilului pentru confidentialitatea datelor.
Securitatea datelor
Succes Servicii Integrate SRL a implementat masuri de protectie pentru a asigura confidentialitatea, securitatea si integritatea datelor cu caracter personal care va privesc. Accesul la datele cu caracter personal este limitat angajatilor care trebuie sa le cunoasca si care au participat la o formare cu privire la normele in materie de confidentialitate.
In cadrul unui site comercial, colectarea coordonatelor bancare se realizeaza intotdeauna cu ajutorul unor procedee eficiente si legale de securizare a platilor: aceste masuri pot consta in codarea SSL (pentru a face datele ilizibile de altii) in timpul colectarii sau transferului de date confidentiale. Aceste coordonate vor fi utilizate doar pentru plata online si nu vor fi pastrate.
Succes Servicii Integrate SRL vegheaza indeosebi ca datele dumneavoastra cu caracter personal sa nu fie modificate, afectate sau accesibile pentru terti.
Cookies
Succes Servicii Integrate SRL colecteaza date referitoare la utilizarea site-urilor internet pentru a oferi servicii mai bune vizitatorilor si utilizatorilor lor, prin utilizarea de „cookies” - fisiere pe care navigatorul de internet le copiaza pe hard discul dumneavoastra atunci cand accesati un site. Fisierele cookies nu permit identificarea dumneavoastra personala. Datele inregistrate pot fi paginile consultate, date si ora consultarii si alte date de monitorizare.
Puteti seta navigatorul astfel incat sa va informeze in legatura cu prezenta cookies-urilor, lasandu-va astfel libertatea de a le accepta sau nu. De asemenea, puteti seta navigatorul pentru a dezactiva cookies-urile.
Servicii interactive
Anumite pagini de internet detinute de Succes Servicii Integrate SRL contin functii interactive (chat, forum, etc.). Puteti utiliza aceste functii prin completarea unui formular de inscriere. Formularul solicita unele date cu caracter personal, cum ar fi numele, adresa, numarul de telefon, adresa electronica. Aceste date sunt colectate doar in scopul de a ameliora serviciile interactive si a va raspunde nevoilor.
Utilizatorii inscrisi la aceste servicii pot avea acces la informatiile furnizate in timpul inscrierii si pot modifica sau sterge in orice moment informatiile furnizate.
Link-uri spre alte pagini de internet
Paginile de internet Succes Servicii Integrate SRL pot contine link-uri spre alte site-uri.Succes Servicii Integrate SRL nu controleaza aceste site-uri si nu poate fi considerat raspunzator pentru practicile lor in materie de confidentialitate sau pentru continutul lor. Din acest motiv, va recomandam sa va informati cu privire la politicile acestor site-uri in ceea ce priveste protectia datelor inainte de a le utiliza sau de a le furniza date cu caracter personal.
Acceptarea prezentelor practici
Prin utilizarea acestui site, acceptati prezentele practici. Daca nu acceptati termenii acestor practici, nu utilizati site-ul si nu furnizati date cu caracter personal.
Modificari
Prezentele practici au fost actualizate luna aceasta. Orice modificare va fi publicata aici si va intra in vigoare la publicarea ei. Din acest motiv va rugam sa consultati periodic aceasta pagina